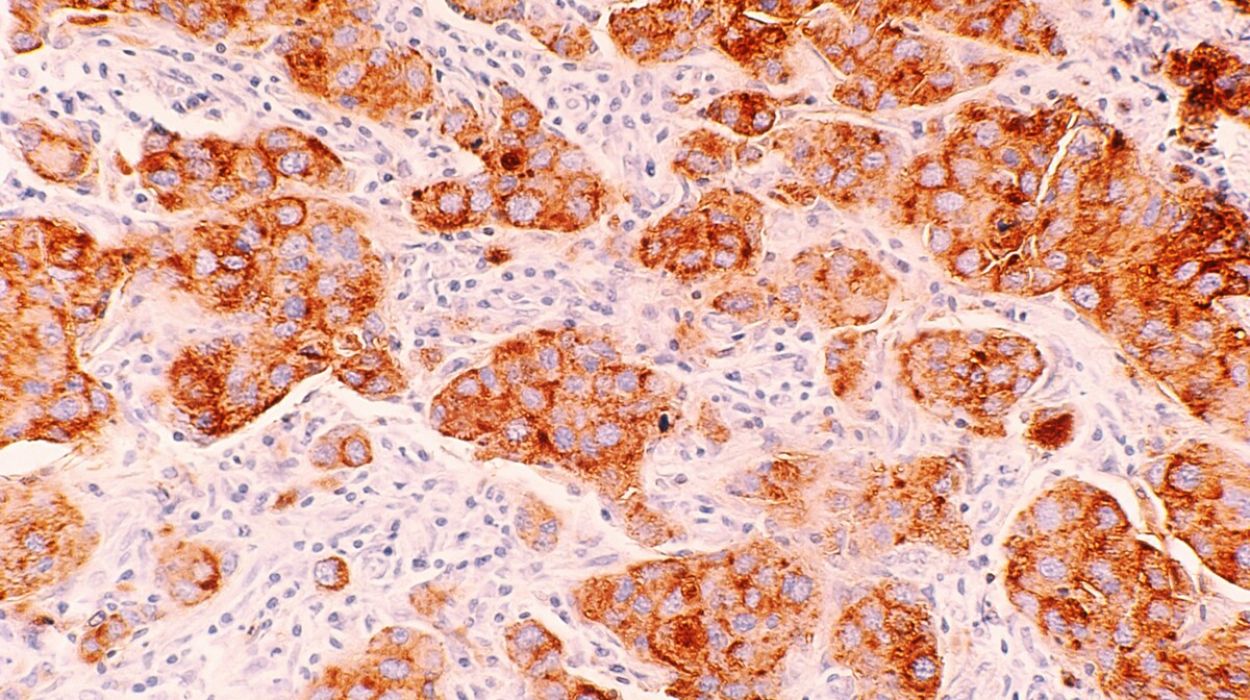

Η νέα γενιά ανοσοθεραπείας και ο καρκίνος
Health
Η νέα γενιά ανοσοθεραπείας φαίνεται να αλλάζει ριζικά τον τρόπο με τον οποίο αντιμετωπίζεται ο καρκίνος, με την επιστημονική κοινότητα να μιλά πλέον για μια πραγματική επανάσταση στην ογκολογία. Οι πρόσφατες εξελίξεις δεν περιορίζονται μόνο στη βελτίωση της ποιότητας ζωής των ασθενών, αλλά δημιουργούν βάσιμες ελπίδες ακόμη και για πλήρη ίαση σε ορισμένες περιπτώσεις.
Ύστερα από δεκαετίες έρευνας και προόδου, οι θεραπείες που αξιοποιούν και ενισχύουν το ανοσοποιητικό σύστημα περνούν σε μια νέα, πιο εξελιγμένη φάση. Αντί να στοχεύουν αποκλειστικά τον όγκο με επιθετικές μεθόδους, όπως η χημειοθεραπεία ή οι χειρουργικές επεμβάσεις, επιδιώκουν να ενεργοποιήσουν τους φυσικούς μηχανισμούς άμυνας του οργανισμού, ώστε να εντοπίζουν και να καταστρέφουν τα καρκινικά κύτταρα με μεγαλύτερη ακρίβεια και λιγότερες παρενέργειες.
Χαρακτηριστικό παράδειγμα αποτελεί η 71χρονη Maureen Sideris, η οποία είχε αντιμετωπίσει καρκίνο του παχέος εντέρου το 2008 με χειρουργική επέμβαση. Χρόνια αργότερα διαγνώστηκε με καρκίνο του οισοφάγου και συμμετείχε σε κλινική δοκιμή στο νοσοκομείο Memorial Sloan Kettering στη Νέα Υόρκη. Αντί να ακολουθήσει τις κλασικές θεραπείες, υποβλήθηκε σε ανοσοθεραπεία με το φάρμακο dostarlimab. Μέσα σε μόλις τέσσερις μήνες, ο όγκος εξαφανίστηκε πλήρως, χωρίς να χρειαστεί χειρουργείο ή χημειοθεραπεία και με ελάχιστες παρενέργειες. Η ίδια, μιλώντας στο BBC, περιέγραψε την εμπειρία της ως «σαν σενάριο επιστημονικής φαντασίας».
Η ανοσοθεραπεία βασίζεται στην ιδέα ότι το ανοσοποιητικό σύστημα μπορεί να «εκπαιδευτεί» ώστε να αναγνωρίζει καλύτερα τα καρκινικά κύτταρα, τα οποία συχνά καταφέρνουν να διαφεύγουν της προσοχής του οργανισμού. Μέσω σύγχρονων τεχνικών, οι επιστήμονες είτε τροποποιούν κύτταρα του ανοσοποιητικού στο εργαστήριο και τα επαναφέρουν στο σώμα για να επιτεθούν στον καρκίνο, είτε μπλοκάρουν τους μηχανισμούς που επιτρέπουν στα καρκινικά κύτταρα να αποφεύγουν την ανοσολογική απόκριση.
Παρά τη σημαντική πρόοδο, η μέθοδος δεν έχει την ίδια αποτελεσματικότητα σε όλους τους ασθενείς. Μόνο ένα ποσοστό, περίπου 20% έως 40%, ανταποκρίνεται θετικά, ενώ σε ορισμένες περιπτώσεις μπορεί να εμφανιστούν σοβαρές παρενέργειες λόγω υπερδιέγερσης του ανοσοποιητικού συστήματος. Επιπλέον, εξακολουθούν να υπάρχουν προκλήσεις στην εφαρμογή αυτών των θεραπειών σε συγκεκριμένους τύπους όγκων, ενώ το υψηλό κόστος και η τεχνολογική πολυπλοκότητα αποτελούν σημαντικά εμπόδια για την ευρεία χρήση τους.
Η σύγχρονη έρευνα στρέφεται ολοένα και περισσότερο προς εξατομικευμένες θεραπείες, που βασίζονται στα γενετικά χαρακτηριστικά κάθε ασθενούς και του όγκου του. Παράλληλα, εξετάζονται συνδυαστικές προσεγγίσεις, όπως η χρήση ανοσοθεραπείας μαζί με ακτινοθεραπεία, αλλά και η ανάπτυξη εμβολίων που «εκπαιδεύουν» το ανοσοποιητικό σύστημα να αναγνωρίζει συγκεκριμένα καρκινικά κύτταρα.
Σε ορισμένες κλινικές μελέτες, ασθενείς με συγκεκριμένα γενετικά χαρακτηριστικά παρουσίασαν πλήρη εξαφάνιση της νόσου μετά από ανοσοθεραπεία, ενισχύοντας την αισιοδοξία για το μέλλον. Παρά τις δυσκολίες, οι επιστήμονες εκτιμούν ότι η ανοσοθεραπεία μπορεί να οδηγήσει σε πιο στοχευμένες, λιγότερο επεμβατικές και πιο αποτελεσματικές θεραπείες, μειώνοντας σταδιακά την ανάγκη για παραδοσιακές μεθόδους όπως η χημειοθεραπεία και η ακτινοθεραπεία και ανοίγοντας τον δρόμο για μια νέα εποχή στην αντιμετώπιση του καρκίνου.
Με πληροφορίες από BBC












